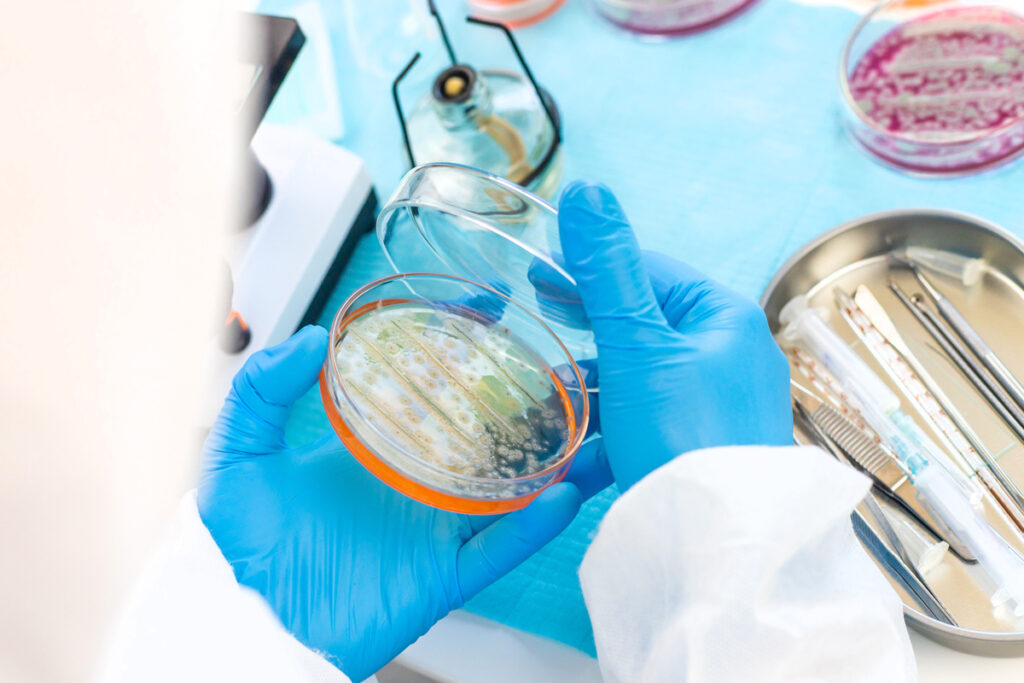
Исследование бактерий в чашках Петри

В 2022 году голландская группа учёных впервые показала: микропластик в крови человека — не гипотеза, а реальность. В образцах крови у большинства добровольцев нашли частицы полиэтилена, ПЭТ и других полимеров, то есть того же материала, из которого делают бутылки и упаковку. Чуть раньше и затем в 2022–2023 годах другие команды обнаружили микропластик в лёгочной ткани живых людей, взятой во время операций: частицы размером всего несколько микрометров застревали глубоко в дыхательных путях.
В 2020–2022 годах итальянские исследователи описали микропластик в плаценте — и на материнской стороне, и на стороне плода, а позже показали его даже внутри клеток. В 2024 году в журнале New England Journal of Medicine вышла работа, где микропластик и нанопластик нашли в атеросклеротических бляшках сонных артерий, а наличие этих частиц связали с более высоким риском инфаркта, инсульта и смерти в течение трёх лет наблюдения.
Одновременно новые оценки показывают: человек может вдыхать десятки тысяч микропластиковых частиц в день, особенно в закрытых, плохо проветриваемых помещениях и салоне автомобиля. То есть микропластик в организме человека — уже не «страшилка экологов», а вполне подтверждённая часть современной биологии. При этом часть громких заявлений вроде «микропластик в каждом органе» недавно подверглась серьёзной критике: часть исследований могли переоценить масштабы из-за загрязнения образцов в лаборатории, и это важное напоминание — данные нужно перепроверять.
Но сам факт постоянного контакта с пластиком, его нахождения в крови, лёгких и плаценте сомнений уже не вызывает. Для конкретного человека вопрос звучит очень просто: влияет ли это на здоровье прямо сейчас, какой реальный вред микропластика и есть ли практический смысл пытаться уменьшить свои личные дозы? Ниже разберём, что уже известно, где границы науки и что можно сделать в повседневной жизни без паники и магических «детоксов».

Что такое микропластик простыми словами
Чтобы понимать масштаб проблемы, важно сначала спокойно ответить на базовый вопрос: что такое микропластик. В современных определениях так называют твёрдые пластиковые частицы размером до 5 миллиметров, а многие эксперты сужают диапазон до фрагментов от примерно одного нанометра до пяти миллиметров в поперечнике.
Для сравнения: пять миллиметров — это ширина тонкого кольца, а частицы в несколько микрометров в десятки раз тоньше человеческого волоса и уже невооружённым глазом их не увидеть. Когда говорят «размер микропластика», обычно имеют в виду диапазон, где частицы ещё можно уловить фильтрами и аналитическими методами, но они уже достаточно малы, чтобы проходить через воду, воздух и, возможно, биологические барьеры.
Ещё мельче — нанопластик, частицы меньше микрона; с ними работают пока считанные лаборатории, и измерять их особенно сложно. По происхождению выделяют два типа: первичный и вторичный микропластик. Первичный — это специально изготовленные мелкие частицы, например микрогранулы в старых скрабах, зубных пастах, промышленный порошок в лакокрасочной или косметической промышленности.
Вторичный микропластик появляется, когда крупные пластиковые изделия — пакеты, бутылки, текстиль, краска, шины — под действием солнца, трения и времени крошатся на мелкие фрагменты. Пластик при этом почти не разлагается химически, он просто ломается на всё более мелкие кусочки, превращаясь сначала в микропластик, а затем в нанопластик.
Поэтому, однажды попав в окружающую среду, пластиковые отходы остаются там на десятилетия и дольше. Для здоровья человека эта устойчивость значит простую вещь: если мы не контролируем выбросы и обращение с пластиком, фон микропластика вокруг и внутри нас будет только расти.

Как микропластик попадает в организм человека
Первый путь — еда.
Частицы находят в морепродуктах, особенно в фильтрующих организмах вроде мидий и устриц, в рыбе, чае из пластиковых пакетиков, порошкообразных продуктах и даже в обычной поваренной соли. Вклад упаковки тоже существенен: при трении и нагреве из пластиковой тары отделяются микрочастицы, которые затем оказываются в готовой пище.
Второй путь — вода.
Обзоры показывают, что микропластик обнаруживают и в водопроводной воде, и в бутилированной, но люди, которые постоянно пьют воду из пластиковых бутылок, в среднем получают значительно больше частиц, иногда до десятков тысяч дополнительно в год по сравнению с теми, кто предпочитает безопасную воду из крана. Важная для практики деталь: часть этих частиц попадает в воду не из природных источников, а прямо из стенок бутылки и крышки, особенно при нагреве, хранении на солнце и многократном использовании тары не по назначению.
Третий путь — воздух.
Микропластик в воздухе — это в первую очередь мелкие волокна от синтетической одежды, обивки мебели, ковров, а также пыль от износа автомобильных шин и дорожного покрытия. Оценки показывают, что человек может вдыхать десятки тысяч микропластиковых частиц в день, причём концентрации в помещении часто выше, чем на улице, а в салоне автомобиля — ещё выше из-за большого количества пластика и слабой вентиляции.
Источник микропластика — не только «где-то в океане», а буквально тарелка с едой, бутылка на столе и воздух в квартире, где мы проводим большую часть жизни.
Где его уже нашли: данные исследований
Сейчас уже можно говорить, что микропластик в организме человека зафиксирован в нескольких типах тканей, но всё ещё по небольшим выборкам. В исследовании, опубликованном в Environment International в 2022 году, голландские учёные проанализировали кровь 22 добровольцев и в примерно 80% образцов обнаружили частицы нескольких видов пластика, в том числе ПЭТ от бутылок и полистирол.
В других работах 2023–2024 годов микропластик в крови связывали с изменениями некоторых показателей свертываемости, но это всё ещё пилотные исследования на десятках людей, а не на тысячах. В 2022 году британская команда показала микропластик в лёгочной ткани, взятой у пациентов во время операций: частицы находили в 11 из 13 образцов, причём и в верхних, и в нижних отделах лёгких.
Итальянская группа ещё в 2020–2021 годах сообщила о микропластике в плаценте: в четырёх из шести плацент нашли двенадцать частиц размером меньше 20 микрометров, распределённых по материнской, плодной сторонам и оболочкам. В 2024 году исследование в New England Journal of Medicine добавило ещё одно звено: в бляшках сонных артерий 257 пациентов нашли полиэтилен и поливинилхлорид, а наличие микропластика и нанопластика ассоциировалось с более чем четырёхкратным ростом риска инфаркта, инсульта или смерти в течение почти трёх лет наблюдений.
Все эти работы имеют общие ограничения: речь идёт о десятках людей, методики сложны и чувствительны к загрязнению, поэтому учёные сами призывают к осторожной интерпретации. Более того, ряд недавних, особенно громких статей о микропластике «во всех органах» сейчас подвергаются жёсткой проверке и критике за возможные методические ошибки и ложноположительные результаты. Тем не менее, даже консервативный набор надёжных исследований уже говорит: частицы пластика способны проходить барьеры организма и накапливаться в ключевых тканях, а это значит, что воздействие не ограничивается только кишечником.

Что происходит после попадания внутрь
После того как микропластик попадает в организм, с ним не происходит никакой «волшебной» химической нейтрализации: пластик остаётся пластиком. Крупные частицы, особенно больше нескольких десятков микрометров, скорее всего, в значительной степени проходят через пищеварительный тракт транзитом и выводятся с калом, как показывают исследования по микропластику в фекалиях.
Более мелкие частицы могут вести себя иначе. Эксперименты на животных и моделях кишечника показывают, что нанопластик и частицы порядка нескольких микрометров способны проникать через стенку кишечника через специализированные клетки или микроповреждения барьера, попадать в лимфу и кровь.
Дальше часть частиц захватывают клетки иммунной системы — макрофаги, которые воспринимают их как чужеродный материал.
В лабораторных условиях это часто сопровождается развитием воспалительной реакции и так называемого окислительного стресса — состояния, когда в клетках слишком много агрессивных кислородсодержащих молекул, способных повреждать белки и ДНК. Всемирная организация здравоохранения в отчётах 2019 и 2022 годов подчёркивает: по совокупности имеющихся данных трудно говорить о чётко доказанном вреде микропластика для здоровья людей на типичных уровнях воздействия, но локальные эффекты на ткани и клетки выглядят правдоподобными, а качество исследований пока неоднородно.
Скорее всего, значительная часть проглоченных частиц выводится, но совсем небольшая фракция действительно может задерживаться в тканях. Чем мельче частицы и чем дольше и выше воздействие, тем выше шанс их проникновения и накопления. При этом у организма нет «специальной системы» для утилизации пластика; он справляется с ним теми же механизмами, что и с любой другой инертной пылью, — барьерами, макрофагами, лимфатическим оттоком.
Поэтому уменьшение входящего потока частиц — единственный реалистичный способ снизить общую нагрузку.

Чем именно он может быть опасен
Потенциальный вред микропластика для здоровья складывается как минимум из трёх механизмов, и важно рассматривать их отдельно.
- Чисто механическое раздражение тканей. Мелкие твёрдые частицы, застревающие в слизистой кишечника или дыхательных путей, могут способствовать хроническому микровоспалению, подобно тому, как пыль и смог ухудшают течение лёгочных заболеваний.
- Микропластик — это переносчик загрязнителей. На его поверхности легко адсорбируются тяжёлые металлы, устойчивые органические соединения и остатки других химикатов, которые могут доставляться к клеткам в более концентрированном виде. В экспериментах на животных такие комплексы усиливали окислительный стресс, вызывали повреждения ДНК и нарушения репродуктивной функции.
- Сам пластик содержит добавки — фталаты, бисфенолы, стабилизаторы, пигменты. Часть из них относится к эндокринным дизрапторам, то есть веществам, способным вмешиваться в работу гормональной системы. Исследования связывают воздействие некоторых пластификаторов с повышенным риском метаболических нарушений, проблем с фертильностью, определённых видов рака, хотя такие связи обычно трудно «отделить» от других факторов образа жизни.
Прямой, однозначной причинно-следственной связи между конкретным количеством микропластика в организме и конкретным заболеванием у людей пока нет. Большинство данных — это лабораторные опыты и наблюдательные исследования, где микропластик идёт «в наборе» с другими загрязнителями, а выборки относительно малы.
Игнорировать проблему нельзя: механизмы возможного вреда выглядят правдоподобно и частично подтверждены на животных. Но и впадать в панику тоже не стоит: по сравнению с курением, гиподинамией, неправильно подобранным питанием вклад микропластика в риск болезней пока явно менее понятен и, вероятно, меньше. Рациональный подход — снижать воздействие там, где это легко и дёшево, и параллельно следить за здоровьем привычными способами.

Микропластик и сердце: что показало новое исследование
Самый обсуждаемый в кардиологии результат 2024 года — как раз о микропластике и сердце.
В исследовании, опубликованном в New England Journal of Medicine, учёные изучили образцы атеросклеротических бляшек, удалённых из сонных артерий у 257 пациентов, перенёсших операцию. В тканях бляшек у значительной части пациентов нашли фрагменты полиэтилена и поливинилхлорида, то есть типичных массовых пластиков, причём концентрации измерялись в микрограммах на миллиграмм ткани.
Затем исследователи проследили за состоянием этих людей почти три года. Оказалось, что у тех, у кого в бляшках обнаружили микропластик и нанопластик, риск комбинированной конечной точки — инфаркта, инсульта или смерти — был примерно в 4,5 раза выше, чем у пациентов без обнаруживаемого микропластика, даже с учётом возраста и других факторов риска.
Это очень пугающий результат, но важно помнить: речь идёт об уже больных людях с тяжёлым атеросклерозом, а не о случайной выборке населения. Кроме того, само наличие микропластика и нанопластика в бляшке не доказывает, что именно они «запустили» процесс. Скорее, они могут быть маркером длительного контакта с загрязнённой средой или сопровождать другие вредные воздействия.
Возможен и обратный сценарий: воспалённая ткань бляшки просто эффективнее «захватывает» частицы, уже циркулирующие в крови. Авторы исследований сами подчёркивают, что речь идёт о корреляции, а не о доказанном причинно-следственном механизме, и призывают к большим многоцентровым исследованиям. Для конкретного человека практический смысл результата таков. Микропластик в крови и сосудах может стать ещё одним фактором, который усугубляет уже существующие кардиориски, особенно на фоне курения, ипертонии, диабета.
Но первым делом всё равно остаются классические шаги — контроль давления, отказ от табака, движение, питание. Снижение воздействия микропластика — разумное дополнение к этим базовым мерам, а не замена.
Особая тема: микропластик в плаценте и возможные риски
Микропластик в плаценте эмоционально воспринимается особенно остро, потому что речь идёт о самом начале жизни.
В исследовании, вошедшем в историю под неофициальным названием «Plasticenta», проанализировали шесть плацент после физиологических беременностей и с помощью рамановской микроспектроскопии нашли двенадцать частиц микропластика в четырёх из них. Частицы были размером от 5 до 10–20 микрометров и находились как на материнской стороне, так и на стороне плода, а также в оболочках. По спектрам их связывали с пигментированными пластиками, использующимися в красках, косметике, упаковке. Более поздние работы той же группы показали, что часть микропластика может находиться внутри клеток плаценты, что делает картину ещё более тревожной.
Однако важно, что эти данные не доказывают, что обнаруженный микропластик вызвал конкретные осложнения беременности или повлиял на здоровье детей — все наблюдаемые беременности протекали нормально. Мы пока не знаем, как часто микропластик в плаценте встречается в популяции, какие дозы критичны и существуют ли пороги безопасности. Обзорные работы подчёркивают, что потенциальные риски включают локальное воспаление, нарушение передачи сигналов гормонов и вмешательство в транспорт питательных веществ и кислорода, но эти выводы основаны в основном на экспериментах на животных и клетках.
Имеет смысл по возможности снижать воздействие пластика: меньше нагревать пищу в пластиковой посуде, по возможности выбирать стеклянную или стальную тару для воды, не злоупотреблять косметикой с блёстками и продуктами с обилием пластиковой пыли, больше проветривать жильё и чаще делать влажную уборку.

Можно ли избавиться от микропластика?
Логичный вопрос после всех этих данных — можно ли вывести микропластик из организма, существует ли реальный «детокс».
Надёжных научных ответов здесь пока мало. Исследования показывают, что часть микропластика действительно выводится естественным путём с калом, и это касается как проглоченных частиц из пищи, так и части того, что попадает в дыхательные пути и затем проглатывается со слизью. При этом неизвестно, какая доля мельчайших частиц задерживается в тканях на годы.
Отдельные работы на животных показывают накопление нанопластика в печени, селезёнке, мозге, но переносить эти цифры напрямую на людей нельзя. Всемирная организация здравоохранения в своих отчётах подчёркивает, что нет подтверждённых методов специфического «выведения микропластика», и главным приоритетом называет снижение внешнего воздействия и улучшение очистки воды и воздуха.
Диеты, добавки, «детокс-курсы», обещающие очистить организм именно от пластика, на сегодня не имеют под собой доказательной базы. В лучшем случае они просто поддерживают общую гигиену жизни — в худшем могут навредить. Единственный реалистичный способ уменьшить микропластик в организме — по возможности сокращать его поступление.
При этом стоит сосредоточиться на мерах с реальной доказательной базой: пить безопасную воду (желательно из проверенного водопровода, а не постоянно из пластиковых бутылок), по возможности использовать фильтры, которые задерживают часть частиц, не разогревать еду в пластиковых контейнерах, не хранить горячие напитки долго в одноразовой пластиковой посуде.
Всё остальное — поддержка нормальной работы организма: достаточное количество клетчатки в рационе, физическая активность, сон. Они не «растворяют» пластик, но помогают кишечнику и иммунной системе функционировать максимально эффективно.

Как снизить воздействие микропластика?
Хорошая новость в истории с микропластиком в том, что часть путей воздействия мы реально контролируем.
- Начнём с воды. Если водопроводная вода в вашем регионе безопасна по микробиологии, её использование с бытовым фильтром часто даёт меньше микропластика, чем постоянное питьё бутилированной воды; причины просты — у пластиковой бутылки и крышки нет шанса «крошиться» при каждом открытии. Обзоры указывают, что именно любители бутилированной воды получают на порядок больше частиц в год. Поэтому практический шаг: по возможности используйте стеклянные или стальные бутылки-повторки, не оставляйте пластиковую тару на солнце и не заливайте в неё кипяток.
- Дальше — питание. Снизить вред микропластика можно, если меньше нагревать еду в пластиковой посуде, особенно в микроволновке, где высокая температура и жиры ускоряют переход частиц в пищу; вместо этого лучше использовать керамику или стекло. Отказ от лишней ультрапереработанной еды тоже помогает: чем больше этапов переработки и упаковки, тем больше шансов контакта с пластиком.
- Затем воздух и пыль. Основной источник микропластика в воздухе квартиры — синтетический текстиль и домашняя пыль, поэтому регулярная влажная уборка, пылесос с HEPA-фильтром и хорошая вентиляция реально снижают количество вдыхаемых частиц; это подтверждают и оценки по микропластику, и более широкий опыт борьбы с пылевым загрязнением. В салоне автомобиля имеет смысл чаще включать приточную вентиляцию и реже ездить с полностью закрытой системой рециркуляции, если это позволяет качество наружного воздуха.
- Наконец, одежда. Синтетика при стирке активно сбрасывает волокна, поэтому полезно стирать такие вещи реже, выбирать деликатные режимы и использовать специальные мешки или фильтры для сбора микроволокон. Это уменьшит выброс микропластика в сточные воды и, в итоге, в окружающую среду.
Вы снижаете собственное вдыхание и проглатывание частиц и одновременно меньше «подкармливаете» общий пластиковый фон, который в будущем вернётся к нам через воду и еду.

Почему полностью избежать микропластика невозможно
Даже если максимально аккуратно выбирать воду, еду и одежду, полностью избежать микропластика сегодня практически нереально. Причина в масштабах производства пластика: по оценкам ООН и международных организаций, мир ежегодно производит более 400 миллионов тонн пластиков, и эта цифра продолжает расти.
Значительная часть — одноразовая упаковка, которая быстро превращается в отходы. Только небольшая доля пластика перерабатывается, остальное сжигается, складируется или попадает в окружающую среду, где крупные предметы неизбежно крошатся до микропластика и нанопластика. К этому добавляются неочевидные источники: износ шин, дорожной разметки, синтетических канатов и сетей, строительные материалы, краски.
Городской образ жизни сам по себе связан с повышенным уровнем микропластика в воздухе и пыли, и даже идеальное поведение одного человека не может полностью компенсировать фон.
Цель «жить без микропластика» нереалистична. Зато реалистично:
- Уменьшить личное воздействие там, где это просто, дёшево и не требует фанатизма.
- Поддерживать системные изменения: от раздельного сбора и локальных инициатив до политических решений, которые реально ограничивают производство и выбросы пластика.
Личный уровень без системного даёт ограниченный эффект, а системный без личного часто упирается в сопротивление потребителей.

Что делают государства и учёные
На уровне политики тема микропластика за последние годы перестала быть узкоспециализированной.
Всемирная организация здравоохранения выпустила два крупных отчёта — о микропластике в питьевой воде и о пищевом и ингаляционном воздействии — и в обоих подчёркивает необходимость стандартизировать методы измерения, снижать загрязнение в природе и параллельно улучшать классические системы очистки воды и сточных вод. Европейский союз в 2023 году принял регламент, который постепенно запрещает намеренно добавляемый микропластик в продуктах: от косметики с микрогранулами и пластиковыми блёстками до некоторых промышленных смесей. Первые запреты, например на микробисер в скрабах и «сыпучий» пластиковый глиттер, уже вступили в силу, а для более сложных применений предусмотрены переходные периоды, чтобы компании успели перейти на другие материалы.
В других странах действуют аналогичные законы, например американский Microbead-Free Waters Act, запрещающий микропластик в косметике, смываемой водой. На глобальном уровне несколько лет идут переговоры о международном договоре по пластику под эгидой ООН. Переговоры продвигаются тяжело: часть стран и компаний настаивает на ограничении самого производства пластика, другие предлагают сосредоточиться только на переработке и управлении отходами; несколько раундов переговоров уже заканчивались без окончательного текста.
Для нас с вами все эти процессы выглядят далёкими, но на деле именно они определяют, сколько пластика будет в мире через десятилетия и насколько тяжёлым окажется общий фон микропластика. Поддержка более жёстких норм, внимание к экологической политике на выборах, выбор компаний, которые реально сокращают пластик, а не только говорят об этом, — всё это инструменты, доступные каждому, кто хочет уменьшить не только свой личный, но и коллективный «пластиковый след».
Как жить в эпоху пластика без паники
Если спокойно подвести спокойный итог, картина получается одновременно тревожной и рациональной. Да, микропластик в организме человека уже обнаружен — в крови, лёгких, плаценте, атеросклеротических бляшках и, возможно, в других тканях. Да, лабораторные и наблюдательные исследования показывают потенциальное влияние микропластика на здоровье — от воспаления и окислительного стресса до возможной связи с сердечно-сосудистыми и гормональными нарушениями, хотя прямые причинно-следственные связи у людей пока не доказаны.Да, мы живём в мире, где производство пластика перевалило за сотни миллионов тонн в год, и полностью уйти от контакта с ним невозможно.
Но при этом важно другое:
- Наука честно признаёт неопределённость и активно пересматривает собственные данные: сомнения в части работ про микропластик в организме — это не «сговор», а нормальный научный процесс.
- Даже неполных данных уже достаточно, чтобы сказать: уменьшать лишнее воздействие микропластика разумно, особенно когда это делается простыми шагами — выбором посуды и одежды, привычками пить воду, уборкой дома.
- На здоровье конкретного человека всё ещё сильнее всего влияют базовые факторы — курение, питание, движение, сон, контроль давления и сахара. Забавно бороться с микропластиком, а потом выкуривать пачку сигарет, не так ли?
Оптимальный подход в эпоху пластика можно сформулировать так: следить за классическими факторами риска, при возможности снижать ненужный контакт с пластиком, поддерживать разумные экологические решения и не поддаваться ни панике, ни циничному «всё равно ничего не изменить». Тогда влияние микропластика на здоровье, даже оставаясь до конца не изученным, будет хотя бы не усиливаться из-за тех вещей, которые мы сами могли бы сделать по-другому.







